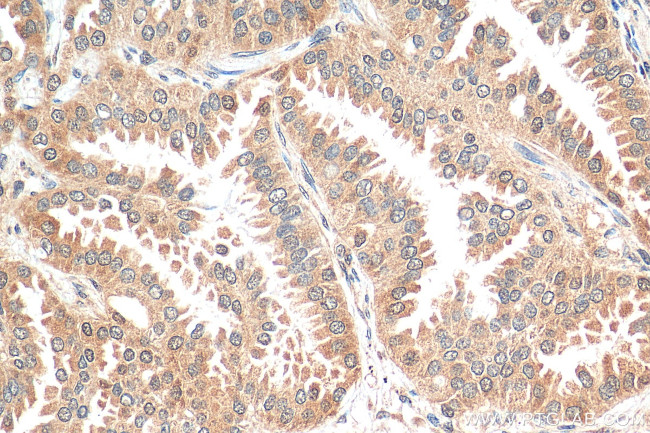
STK11/LKB1 Antibody in Immunohistochemistry (Paraffin) (IHC (P))

Search
Proteintech
STK11/LKB1 Polyclonal Antibody
{{$productOrderCtrl.translations['antibody.pdp.commerceCard.promotion.promotions']}}
{{$productOrderCtrl.translations['antibody.pdp.commerceCard.promotion.viewpromo']}}
{{$productOrderCtrl.translations['antibody.pdp.commerceCard.promotion.promocode']}}: {{promo.promoCode}} {{promo.promoTitle}} {{promo.promoDescription}}. {{$productOrderCtrl.translations['antibody.pdp.commerceCard.promotion.learnmore']}}
产品信息
29323-1-AP
种属反应
宿主/亚型
分类
类型
抗原
偶联物
形式
纯化类型
保存液
内含物
保存条件
运输条件
产品详细信息
Immunogen sequence: PLSDLLKGML EYEPAKRFSI RQIRQHSWFR KKHPPAEAPV PIPPSPDTKD RWRSMTVVPY LEDLHGADED EDLFDIEDDI IYTQDFTVPG QVPEEEASHN GQRRGLPKAV CMNGTEAAQL STKSRAEGRA PNPARKACSA SSKIRRLS
靶标信息
LKB1 (also known as STK11 - Serine/threonine-protein kinase STK11), a member of the serine/threonine kinase family, is a tumor suppressor. LKB1 physically associates with p53 and regulates specific p53 dependent apoptosis pathways. LKB1 is present in both the cytoplasm and nucleus of living cells and translocates to mitochondria during apoptosis. LKB1 functions as a master upstream protein kinase, regulating AMPK related kinases as well as AMPK. Mutations in LKB1 gene are associated with Peutz Jeghers syndrome.
仅用于科研。不用于诊断过程。未经明确授权不得转售。
篇参考文献 (0)
生物信息学
蛋白别名: CAMK group; CAMKL family; Liver kinase B1; Liver kinase B1 homolog; LKB 1; LKB-1; LKB1; LKB1(S); polarization-related protein LKB1; Renal carcinoma antigen NY-REN-19; serine/threonine kinase 11; STK11; serine/threonine-protein kinase 11; serine/threonine-protein kinase LKB1; Serine/threonine-protein kinase STK11; unnamed protein product
基因别名: AA408040; hLKB1; LKB1; Par-4; PJS; R75140; STK11
UniProt ID: (Human) Q15831, (Mouse) Q9WTK7
Entrez Gene ID: (Human) 6794, (Mouse) 20869